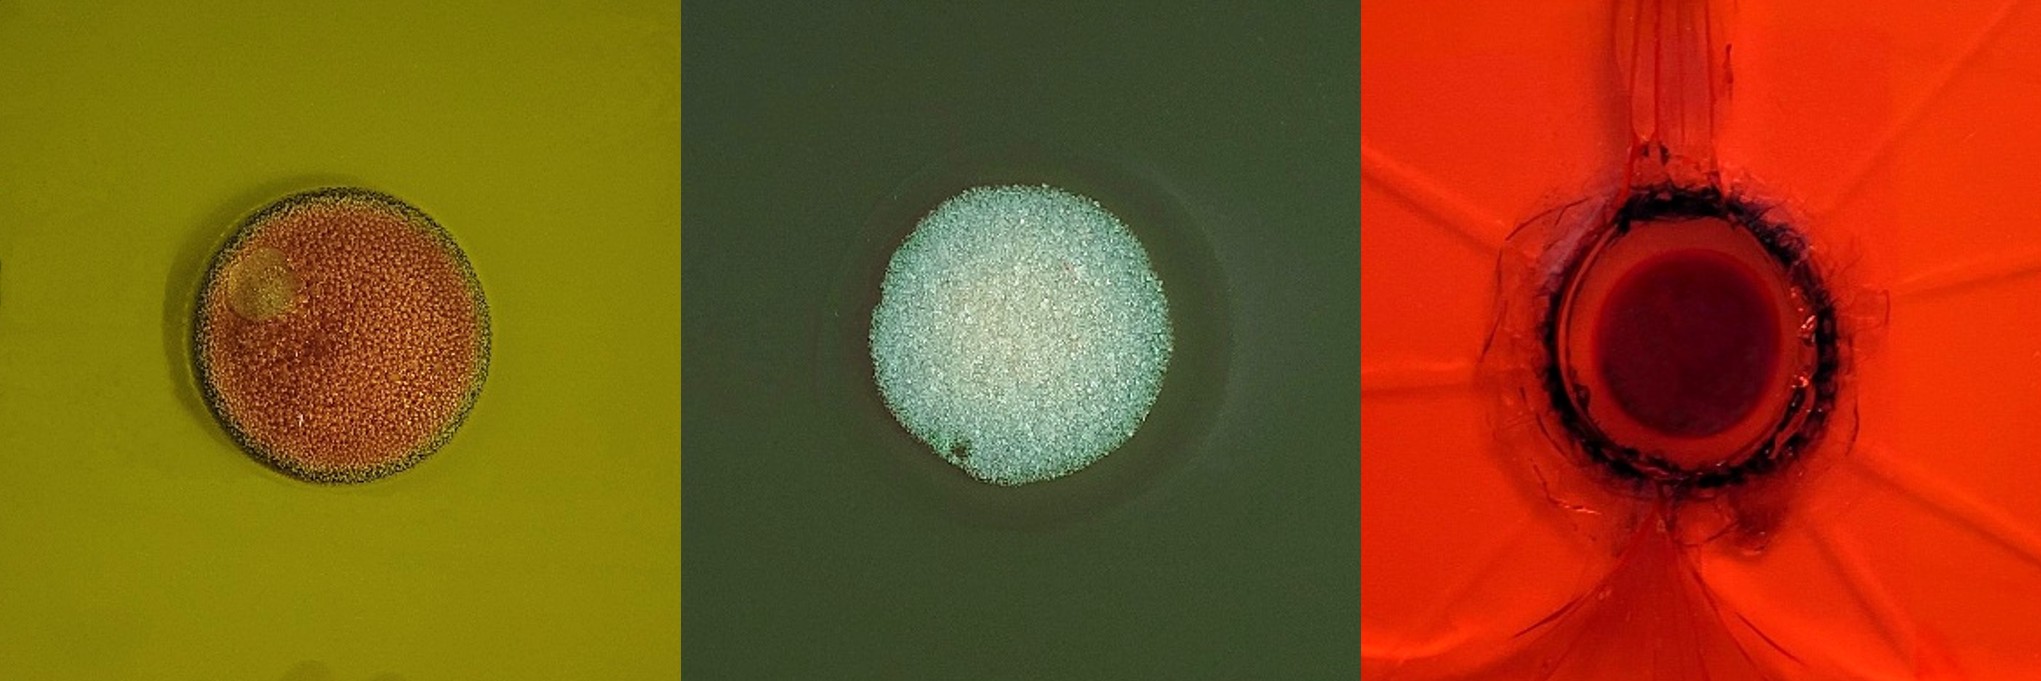
Banner: Auswahl an geprüften Laserschutzfenstern aus PC, PMMA sowie Glas (Quelle: Bayerisches Laserzentrum GmbH)

Im Fokus des Forschungsvorhabens steht die beschleunigte Entwicklung von Tintenstrahldruckköpfen für spezielle Anwendungen.
Die Dosierung kleinster Fluidmengen unter Verwendung des Drop-on-Demand-Verfahrens ist nicht nur in Anwendungen wie z.B. dem Grafikdruck von Bedeutung, sondern bietet auch Ansätze, für die Entwicklung völlig neuer Technologien. So spielen zum Beispiel im Mikro-3-D-Druck Medien wie Lösemittel oder in der Medizintechnik Flüssigkeiten, die mit Partikeln versetzt sind, eine wichtige Rolle. Hierbei ist die Reproduzierbarkeit der erzielten Tropfeneigenschaften essenziell. Von steigender Bedeutung sind Tropfenerzeuger, die eine Anpassung an unterschiedliche Fluide erlauben. Es ist daher wichtig, die Tropfenbildung in einem vorhersagbaren Prozess durchzuführen, in dem die Tropfenmassen, -volumen und Massenströme exakt eingestellt werden können.


rechts: Rasterelektronenmikroskopische Aufnahme der Silizium-Grundplatte mit Düse, Pumpkammer, Drossel und Fluidzuführung (Quelle: Technische Universität München, Lehrstuhl für Mikrotechnik und Medizintechnik)
Im Verlauf des Forschungsprojekts wurden dazu ein Referenzdesign, ein adaptierbares Testfluid und eine Softwareumgebung für die automatische Dimensionierung entwickelt. Das Referenzdesign wird auf einem Siliziumchip realisiert. Die Kanäle und Kammern für die Flüssigkeitsführung werden durch Laserablation eingearbeitet. Die Düse, durch die später der Tropfenausstoß stattfindet, wird durch ein Mikroschleifverfahren aus der Halbleitertechnik das hohen Anforderungen an die Oberflächengüte genügt, hergestellt. Die fluidführenden Strukturen werden durch eine dünne Glasmembran verschlossen. Die Verbindung erfolgt Klebstofffrei durch anodisches Bonden, ein Verbindungsverfahren für Silizium und Borosilikatglas. Auf die so entstandene Pumpkammer wird abschließend die Piezokeramik aufgeklebt. Nach der elektrischen Kontaktierung kann durch Anlegen einer Spannung eine Volumenänderung der Pumpkammer erzielt werden, die den Tropfenausstoß hervorruft.
Um den Einfluss der Flüssigkeitseigenschaften zu ermitteln, wurde ein Modelfluid, bei dem es sich um ein tertiäres Gemisch von Wasser, Isopropanol und Glycerin handelt, entwickelt. Durch Variation der Stoffmengenanteile können hierbei die Eigenschaften Viskosität und Oberflächenspannung in einem weiten Bereich unabhängig voneinander eingestellt werden. Die entwickelte Auslegungssoftware nimmt für die Berechnung Zielparameter der Anwendung über die Benutzerschnittstelle entgegen. Dabei stehen die Eigenschaften des Arbeitsfluids sowie die gewünschten Tropfeneigenschaften wie Größe und Geschwindigkeit im Vordergrund. Die durchgeführte Validierung des Modelles zeigt, dass eine gute Übereinstimmung mit der Realität erzielt wird. Hierdurch konnte der Nutzen für praktische Anwendungen belegt werden.